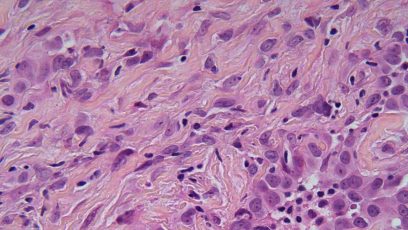

WCLC2020: Opløftende data for patienter med recidiverende malign mesotheliom
Hør Jens Benn Sørensen perspektivere resultaterne fra CONFIRM-studiet, der viser interessante data for behandling med nivolumab monoterapi til patienter med recidiverende malign mesotheliom.